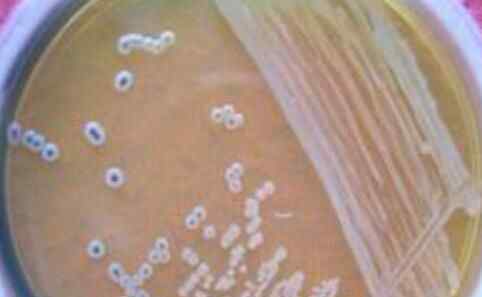

据爱尔兰《新岛周报》报道,经调查发现,一种名为产碳青霉烯酶肠杆菌(简称CpE)的超级病菌正在爱尔兰利默里克大学医院蔓延,有8名病人的死因与这种病菌有关。
报道称,CpE是最难被抗生素杀死的病菌之一,一旦进入血管,会加速多器官衰竭,从而危及生命。
经检查,利默里克大学医院有8名病人的死亡与CpE有关。虽然这些病人先前都患有非常严重的疾病,最后的死因也不完全是CpE侵入而造成的,但CpE在其中扮演“推波助澜”的角色还是引起了专家们注意。

CpE早在2009年就有在利默里克大学医院扩散的迹象,2011年发生了首个入侵案例,后来病菌传播到了其他医院。
现在各方人士都在努力阻止CpE蔓延,并且已经取得了很大成效。目前专家正在对医院内部进行筛检,同时对曾患过CpE并发症的人们进行跟踪走访,以获得这种病菌更多的信息。
专家表示,目前大众还不需要对此太过于焦虑,情况处于掌控中。
1.《爱尔兰现超级病菌 可怕至极真相让人吓尿了》援引自互联网,旨在传递更多网络信息知识,仅代表作者本人观点,与本网站无关,侵删请联系页脚下方联系方式。
2.《爱尔兰现超级病菌 可怕至极真相让人吓尿了》仅供读者参考,本网站未对该内容进行证实,对其原创性、真实性、完整性、及时性不作任何保证。
3.文章转载时请保留本站内容来源地址,https://www.lu-xu.com/junshi/1392408.html











